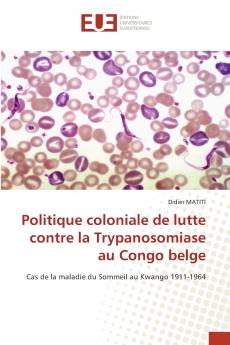
Politique coloniale de lutte contre la Trypanosomiase au Congo belge
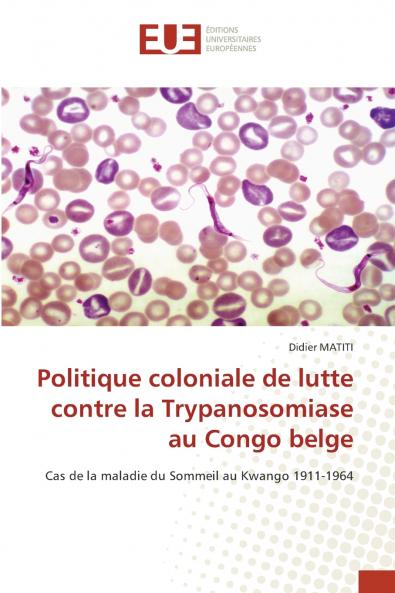
Politique coloniale de lutte contre la Trypanosomiase au Congo belge

French
Paperback
₹4329
₹6023
28.13% OFF
(All inclusive*)
Delivery Options
Please enter pincode to check delivery time.
*COD & Shipping Charges may apply on certain items.
Review final details at checkout.
Looking to place a bulk order? SUBMIT DETAILS
About The Book
Description
Author
Le sujet que nous nous sommes permis d'étudier s'intitule : Politique coloniale de lutte contre la maladie du sommeil. Cas du district de Kwango (1911-1964). Ce sujet nous a en effet permis de nous rendre compte de l'impact combien important de la Trypanosomiase humaine dans le monde et dans notre pays. Nous avons donc tenté d'apporter notre petite contribution aux problèmes des maladies dans notre pays.
Delivery Options
Please enter pincode to check delivery time.
*COD & Shipping Charges may apply on certain items.
Review final details at checkout.
Details
ISBN 13
9786206731597
Publication Date
-29-01-2025
Pages
-52
Weight
-85 grams
Dimensions
-152x229x3.16 mm